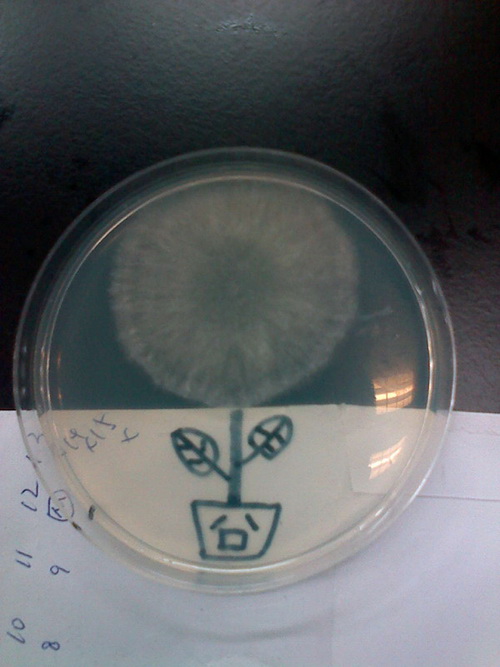

主要职责
中国科学院贯彻落实党中央关于科技创新的方针政策和决策部署,在履行职责过程中坚持党中央对科技工作的集中统一领导。主要职责是:
一、开展使命导向的自然科学领域基础研究,承担国家重大基础研究、应用基础研究、前沿交叉共性技术研究和引领性颠覆性技术研究任务,打造原始创新策源地。 更多+
院况简介
中国科学院是国家科学技术界最高学术机构、国家科学技术思想库,自然科学基础研究与高技术综合研究的国家战略科技力量。
1949年,伴随着新中国的诞生,中国科学院成立。建院70余年来,中国科学院时刻牢记使命,与科学共进,与祖国同行,以国家富强、人民幸福为己任,人才辈出,硕果累累,为我国科技进步、经济社会发展和国家安全作出了不可替代的重要贡献。 更多+
院领导集体
科技奖励
科技期刊
科技专项
科研进展/ 更多
工作动态/ 更多
工作动态/ 更多
中国科学院学部
中国科学院院部
语音播报
中国科学院上海生命科学研究院生物化学与细胞生物学研究所第六届“科研人的生活”摄影大赛于4月至6月在研究所成功举行,比赛共收到作品百余幅。按大赛评分规则,比赛分值比例由初评、微博投票及现场投票三部分组成。
经过近一个月的展示及观众投票,近日,最终作品《这里风景独好》获特等奖,《奇妙的滴管》获一等奖,《320的春天》《细胞楼顶的夜幕》《软座就是舒服》《实验室的小花》《向着太阳生长》分获大赛二、三等奖。
2015年恰逢人工全合成结晶牛胰岛素50周年,生化与细胞所学生会选定“科研人的生活”为本次大赛主题,期望“以赛会友”,汇聚研究所各方摄影爱好者,增进彼此交流与互信,更为紧张工作之余的科研人们带来些许美好与温暖,以此向老一辈科学家们致敬。

特等奖 《这边风景独好》 陈正军组 戴衍

一等奖 《奇妙的滴管》 曾艺组 王经强

二等奖 《细胞楼顶的夜幕》 姜海组 丁宏宇

二等奖 《320的春天》 朱学良组 李昊

三等奖 《软座就是舒服》 陈正军组 戴衍

三等奖 《实验室的小花》 姜海组 赵洁
三等奖 《苦中作乐的科研生活3 向着太阳生长》 高大明组 刘相元
扫一扫在手机打开当前页
© 1996 - 中国科学院 版权所有 京ICP备05002857号-1
京公网安备110402500047号 网站标识码bm48000002
地址:北京市西城区三里河路52号 邮编:100864
电话: 86 10 68597114(总机) 86 10 68597289(总值班室)








